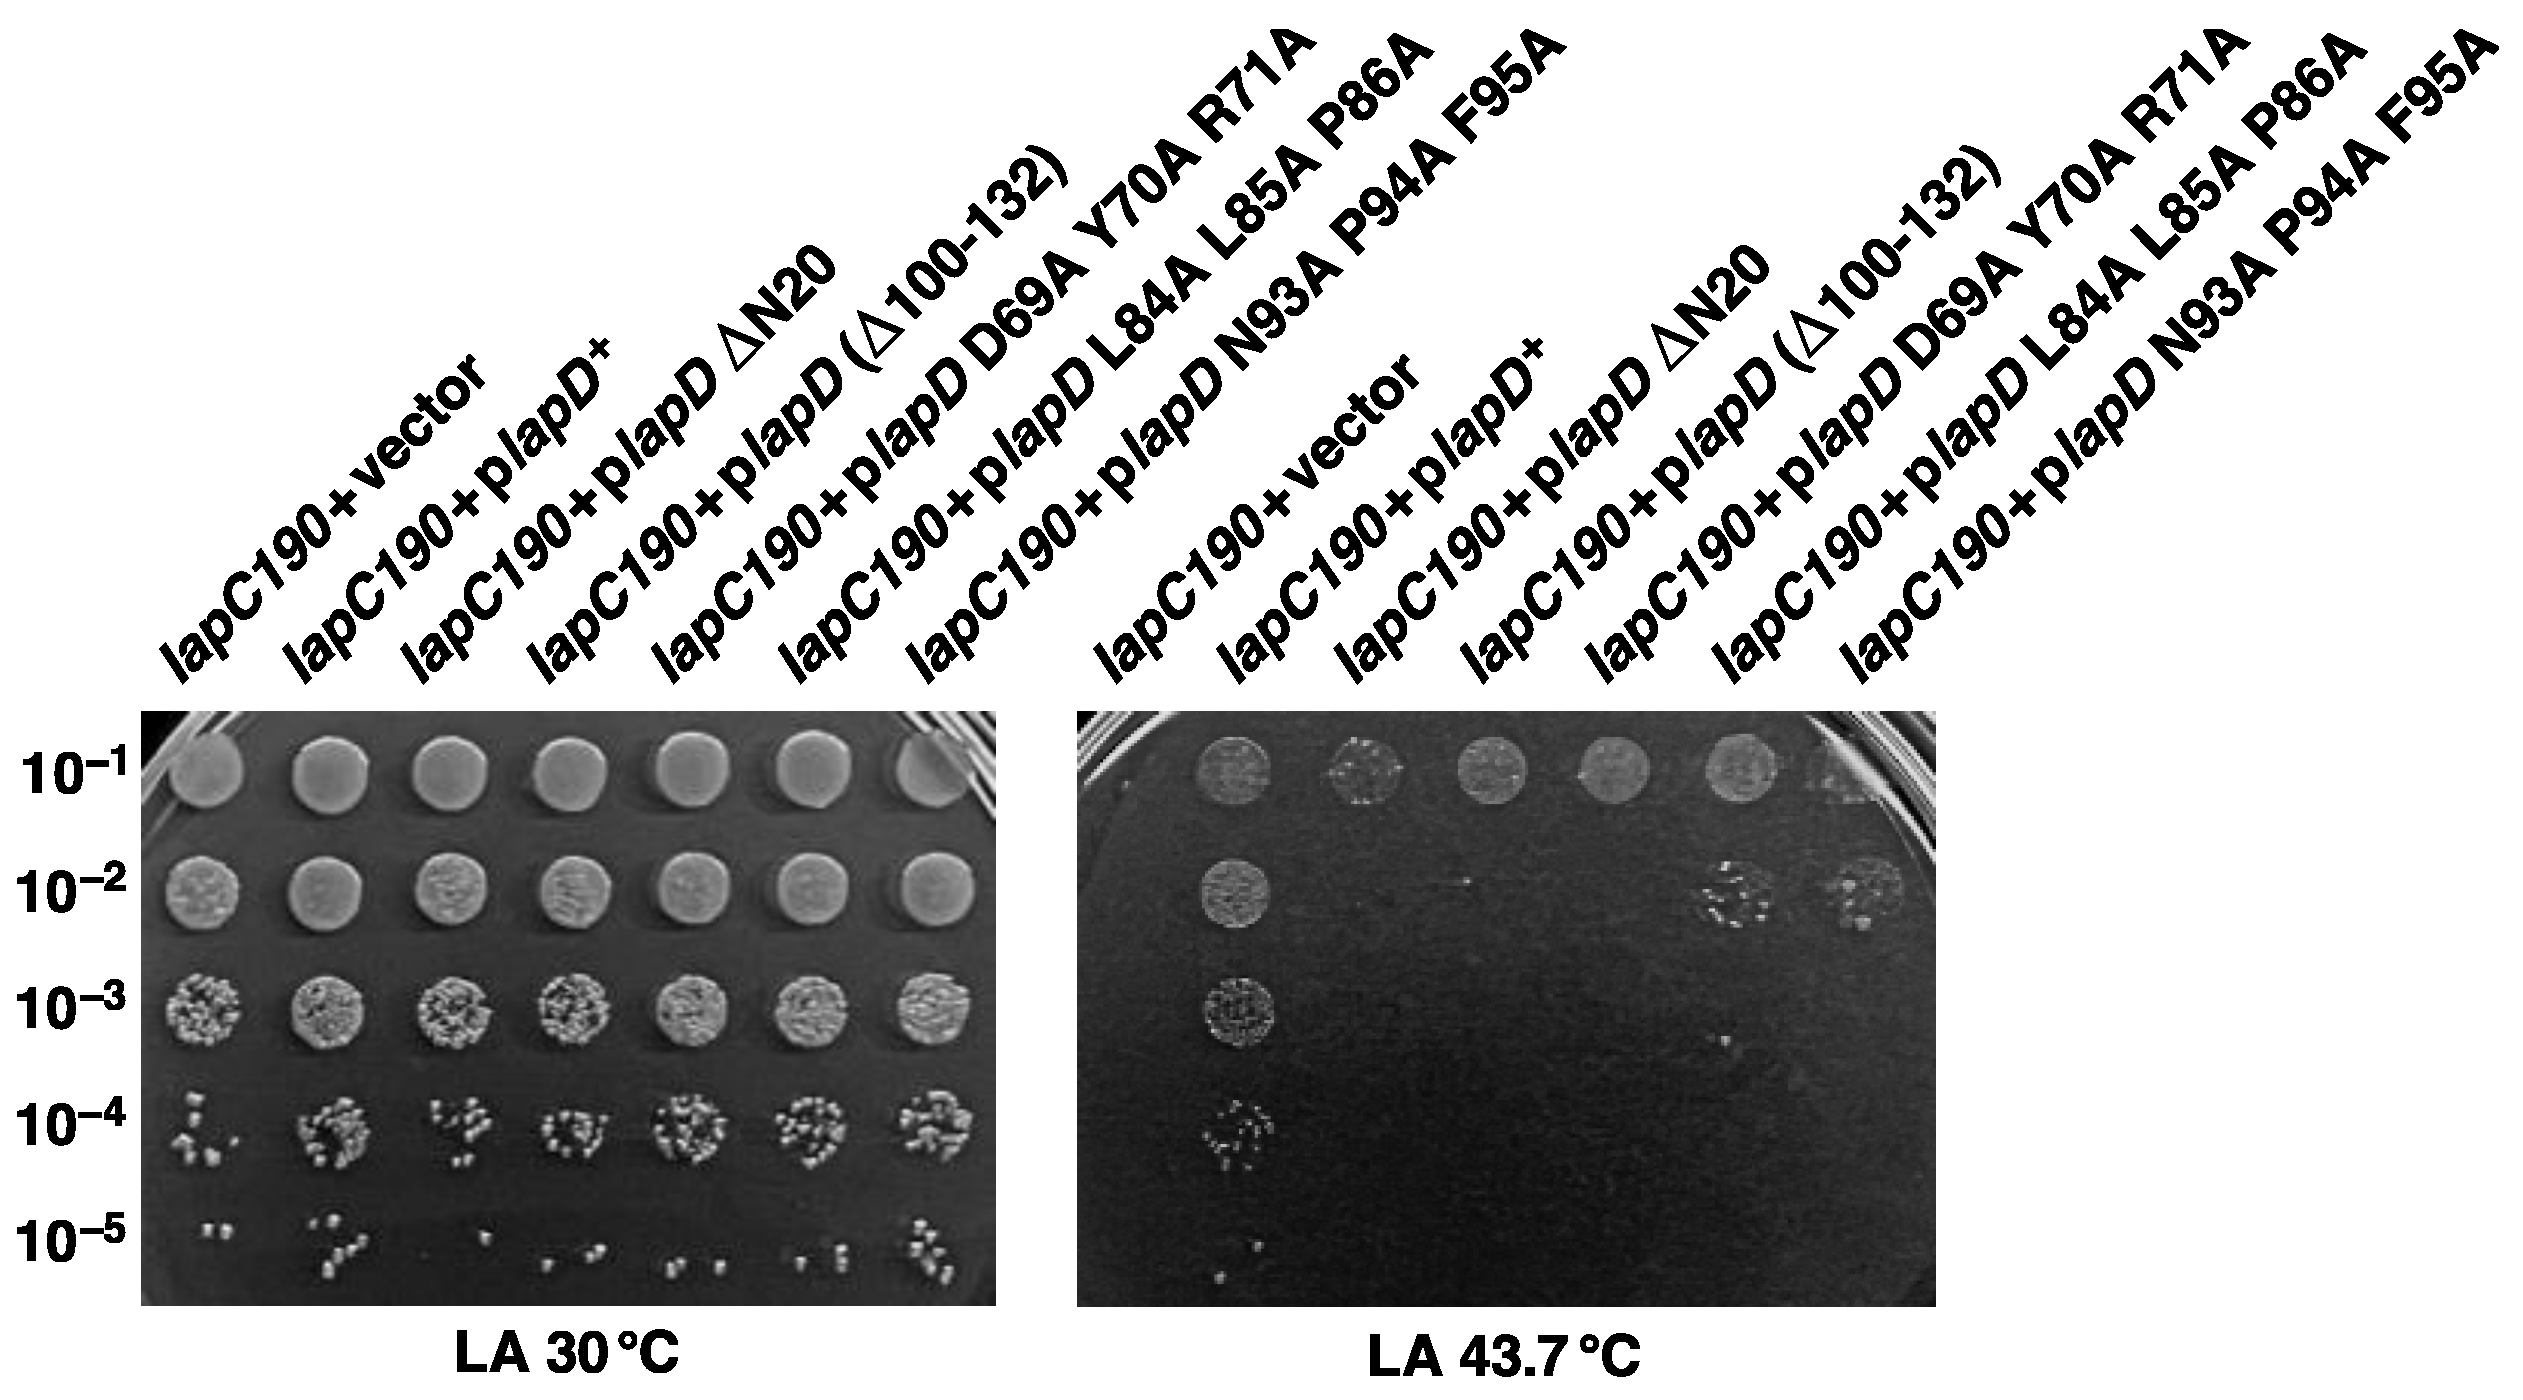
Ijms 24 15174 g009 Ijms 24 15174 g009

Suppressors of lapC Mutation Identify New Regulators of LpxC, Which Mediates the First Committed Step in Lipopolysaccharide Biosynthesis
Abstract
1. Introduction
2. Results
2.1. Genes Whose Overexpression Overcomes the Temperature Sensitivity (Ts) of lapC Mutant Bacteria with a Truncation of LapC Periplasmic Domain Identify New Players That Can Regulate LpxC Amounts
2.2. Overexpression of srrA, marA, yceJ and yfgM Restore LpxC Amounts in lapC Mutant Bacteria
2.3. Overexpression of srrA, marA, yceJ and dksA also Restore LPS Amounts in lapC190 Bacteria
2.4. srrA, marA, lapD and pldA Are Indispensable in the lapC190 Mutant Background
2.5. Lauroyl and Myristoyl Transferases Are Required for the Viability of lapC190 Mutant Bacteria
2.6. MarA-Mediated Suppression Requires the Presence of mla Genes
2.7. Absence of mla Genes Does Not Alter LPS Composition
2.8. SrrA-Mediated Suppression of lapC190 Mutant Bacteria Requires the Presence of Cardiolipin Synthase A and ClsA Is Essential for lapC190
2.9. SrrA Does Not Regulate Transcription of the clsA Gene
2.10. LapD-Mediated Suppression of a lapC190 Mutant Bacteria Requires LapD N- and C-Terminal Domains and Identification of Some of the Critical Amino Acid Residues Required for LapD Function
2.11. Multicopy Suppression of lapC190 Bacterial Defects Requires DksA’s PPIase and Transcriptional Activities
3. Discussion
4. Materials and Methods
4.1. Bacterial Strains, Plasmids and Media
4.2. Identification of Multicopy Suppressors Whose Overexpression Suppresses the Temperature-Sensitive Phenotype of lapC190 Bacteria
4.3. The Isolation of Chromosomal Transposon Insertion Mutations That Prevent the Suppression by Overexpression of Either the marA Gene or the srrA Gene
4.4. Estimation of LpxC Amounts by Immunoblotting
4.5. Site-Directed Mutagenesis of the lapD Gene and In Vivo Complementation Analysis
4.6. LPS Extraction, Mass Spectrometry and Measurement of LPS Levels
4.7. RNA Purification and qRT-PCR Analysis
4.8. Bacterial Growth Analysis
Author Contributions
Funding
Institutional Review Board Statement
Informed Consent Statement
Data Availability Statement
Acknowledgments
Conflicts of Interest
References
- Nikaido, H. Molecular basis of bacterial outer membrane permeability revisited. Microbiol. Mol. Biol. Rev. 2003, 67, 593–656. [Google Scholar] [CrossRef] [PubMed]
- Klein, G.; Raina, S. Regulated control of the assembly and diversity of LPS by noncoding sRNAs. BioMed. Res. Int. 2015, 2015, 153561. [Google Scholar] [CrossRef] [PubMed]
- Raetz, C.R.H.; Whitfield, C. Lipopolysaccharide endotoxins. Annu. Rev. Biochem. 2002, 71, 635–700. [Google Scholar] [CrossRef] [PubMed]
- Mohan, S.; Kelly, T.M.; Eveland, S.S.; Raetz, C.R.; Anderson, M.S. An Escherichia coli gene (fabZ) encoding (3R)-hydroxymyristoyl acyl carrier protein dehydrase. Relation to fabA and suppression of mutations in lipid A biosynthesis. J. Biol. Chem. 1994, 269, 32896–32903. [Google Scholar] [CrossRef]
- Ogura, T.; Inoue, K.; Tatsuta, T.; Suzaki, T.; Karata, K.; Young, K.; Su, L.H.; Fierke, C.A.; Jackman, J.E.; Raetz, C.R.H.; et al. Balanced biosynthesis of major membrane components through regulated degradation of the committed enzyme of lipid A biosynthesis by the AAA protease FtsH (HflB) in Escherichia coli. Mol. Microbiol. 1999, 31, 833–844. [Google Scholar] [CrossRef]
- Biernacka, D.; Gorzelak, P.; Klein, G.; Raina, S. Regulation of the first committed step in lipopolysaccharide biosynthesis catalyzed by LpxC requires the essential protein LapC (YejM) and HslVU protease. Int. J. Mol. Sci. 2020, 21, 9088. [Google Scholar] [CrossRef]
- Anderson, M.S.; Raetz, C.R. Biosynthesis of lipid A precursors in Escherichia coli. A cytoplasmic acyltransferase that converts UDP-N-acetylglucosamine to UDP-3-O-(R-3-hydroxymyristoyl)-N-acetylglucosamine. J. Biol. Chem. 1987, 262, 5159–5169. [Google Scholar] [CrossRef]
- Young, K.; Silver, L.L.; Bramhill, D.; Cameron, P.; Eveland, S.S.; Raetz, C.R.; Hyland, S.A.; Anderson, M.S. The envA permeability/cell division gene of Escherichia coli encodes the second enzyme of lipid A biosynthesis. UDP-3-O-(R-3-hydroxymyristoyl)-N-acetylglucosamine deacetylase. J. Biol. Chem. 1995, 270, 30384–30391. [Google Scholar] [CrossRef]
- Anderson, M.; Bull, H.; Galloway, S.; Kelly, T.; Mohan, S.; Radika, K.; Raetz, C. UDP-N-acetylglucosamine acyltransferase of Escherichia coli. The first step of endotoxin biosynthesis is thermodynamically unfavorable. J. Biol. Chem. 1993, 268, 19858–19865. [Google Scholar] [CrossRef]
- Bartling, C.M.; Raetz, C.R.H. Steady-state kinetics and mechanism of LpxD, the N-acyltransferase of lipid A biosynthesis. Biochemistry 2008, 47, 5290–5302. [Google Scholar] [CrossRef]
- Raetz, C.R.; Guan, Z.; Ingram, B.O.; Six, D.A.; Song, F.; Wang, X.; Zhao, J. Discovery of new biosynthetic pathways: The lipid A story. J. Lipid Res. 2009, 50, S103–S108. [Google Scholar] [CrossRef] [PubMed]
- Belunis, C.J.; Raetz, C.R. Biosynthesis of endotoxins. Purification and catalytic properties of 3-deoxy-D-manno-octulosonic acid transferase from Escherichia coli. J. Biol. Chem. 1992, 267, 9988–9997. [Google Scholar] [CrossRef] [PubMed]
- Klein, G.; Lindner, B.; Brabetz, W.; Brade, H.; Raina, S. Escherichia coli K-12 suppressor-free mutants lacking early glycosyltransferases and late acetyltransferases: Minimal lipopolysaccharide structure and induction of envelope stress response. J. Biol. Chem. 2009, 284, 15369–15389. [Google Scholar] [CrossRef] [PubMed]
- Vorachek-Warren, M.K.; Ramirez, S.; Cotter, R.J.; Raetz, C.R.H. A triple mutant of Escherichia coli lacking secondary acyl chains on lipid A. J. Biol. Chem. 2002, 277, 14194–14205. [Google Scholar] [CrossRef] [PubMed]
- Gorzelak, P.; Klein, G.; Raina, S. Molecular basis of essentiality of early critical steps in the lipopolysaccharide biogenesis in Escherichia coli K-12: Requirement of MsbA, cardiolipin, LpxL, LpxM and GcvB. Int. J. Mol. Sci. 2021, 22, 5099. [Google Scholar] [CrossRef] [PubMed]
- Douglass, M.V.; Cléon, F.; Trent, M.S. Cardiolipin aids in lipopolysaccharide transport to the gram-negative outer membrane. Proc. Natl. Acad. Sci. USA 2021, 118, e2018329118. [Google Scholar] [CrossRef]
- Klein, G.; Wieczorek, A.; Szuster, M.; Raina, S. Checkpoints that regulate balanced biosynthesis of lipopolysaccharide and its essentiality in Escherichia coli. Int. J. Mol. Sci. 2021, 23, 189. [Google Scholar] [CrossRef]
- Sorensen, P.G.; Lutkenhaus, J.; Young, K.; Eveland, S.S.; Anderson, M.S.; Raetz, C.R. Regulation of UDP-3-O-[R-3-hydroxymyristoyl]-N-acetylglucosamine deacetylase in Escherichia coli: The second enzymatic step of lipid a biosynthesis. J. Biol. Chem. 1996, 271, 25898–25905. [Google Scholar] [CrossRef]
- Klein, G.; Kobylak, N.; Lindner, B.; Stupak, A.; Raina, S. Assembly of lipopolysaccharide in Escherichia coli requires the essential LapB heat shock protein. J. Biol. Chem. 2014, 289, 14829–14853. [Google Scholar] [CrossRef]
- Mahalakshmi, S.; Sunayana, M.R.; SaiSree, L.; Reddy, M. yciM is an essential gene required for regulation of lipopolysaccharide synthesis in Escherichia coli. Mol. Microbiol. 2014, 91, 145–157. [Google Scholar] [CrossRef]
- Möller, A.M.; Brückner, S.; Tilg, L.J.; Kutscher, B.; Nowaczyk, M.M.; Narberhaus, F. LapB (YciM) orchestrates protein-protein interactions at the interface of lipopolysaccharide and phospholipid biosynthesis. Mol. Microbiol. 2023, 119, 29–43. [Google Scholar] [CrossRef] [PubMed]
- Shu, S.; Mi, W. Regulatory mechanisms of lipopolysaccharide synthesis in Escherichia coli. Nat. Commun. 2022, 13, 4576. [Google Scholar] [CrossRef] [PubMed]
- Guest, R.L.; Samé Guerra, D.; Wissler, M.; Grimm, J.; Silhavy, T.J. YejM modulates activity of the YciM/FtsH protease complex to prevent lethal accumulation of lipopolysaccharide. mBio 2020, 11, e00598-20. [Google Scholar] [CrossRef] [PubMed]
- Clairfeuille, T.; Buchholz, K.R.; Li, Q.; Verschueren, E.; Liu, P.; Sangaraju, D.; Park, S.; Noland, C.L.; Storek, K.M.; Nickerson, N.N.; et al. Structure of the essential inner membrane lipopolysaccharide-PbgA complex. Nature 2020, 584, 479–483. [Google Scholar] [CrossRef] [PubMed]
- Fivenson, E.M.; Bernhardt, T.G. An essential membrane protein modulates the proteolysis of LpxC to control lipopolysaccharide synthesis in Escherichia coli. mBio 2020, 11, e00939-20. [Google Scholar] [CrossRef]
- Nguyen, D.; Kelly, K.; Qiu, N.; Misra, R. YejM controls LpxC levels by regulating protease activity of the FtsH/YciM complex of Escherichia coli. J. Bacteriol. 2020, 202, e00303-20. [Google Scholar] [CrossRef]
- Cian, M.B.; Giordano, N.P.; Masilamani, R.; Minor, K.E.; Delabroux, Z.D. Salmonella enterica serovar Typhimurium uses PdgA/YejM to regulate lipopolysaccharide assembly during bacteremia. Infect. Immun. 2020, 88, e00758-19. [Google Scholar]
- Wieczorek, A.; Sendobra, A.; Maniyeri, A.; Sugalska, M.; Klein, G.; Raina, S. A new factor LapD is required for the regulation of LpxC amounts and lipopolysaccharide trafficking. Int. J. Mol. Sci. 2022, 23, 9706. [Google Scholar] [CrossRef]
- Goodall, E.C.A.; Isom, G.L.; Rooke, J.L.; Pullela, K.; Icke, C.; Yang, Z.; Boelter, G.; Jones, A.; Warner, I.; Da Costa, R.; et al. Loss of YhcB results in dysregulation of coordinated peptidoglycan, LPS and phospholipid synthesis during Escherichia coli cell growth. PLoS Genet. 2021, 17, e1009586. [Google Scholar] [CrossRef]
- May, K.L.; Silhavy, T.J. The Escherichia coli phospholipase PldA regulates outer membrane homeostasis via lipid signaling. mBio 2018, 9, e00379-18. [Google Scholar] [CrossRef]
- Emiola, A.; Andrews, S.S.; Heller, C.; George, J. Crosstalk between the lipopolysaccharide and phospholipid pathways during outer membrane biogenesis in Escherichia coli. Proc. Natl. Acad. Sci. USA 2016, 113, 3108–3113. [Google Scholar] [CrossRef]
- Kettles, R.A.; Tschowri, N.; Lyons, K.J.; Sharma, P.; Hengge, R.; Webber, M.A.; Grainger, D.C. The Escherichia coli MarA protein regulates the ycgZ-ymgABC operon to inhibit biofilm formation. Mol. Microbiol. 2019, 112, 1609–1625. [Google Scholar] [CrossRef] [PubMed]
- Kitagawa, M.; Ara, T.; Arifuzzaman, M.; Ioka-Nakamichi, T.; Inamoto, E.; Toyonaga, H.; Mori, H. Complete set of ORF clones of Escherichia coli ASKA library (a complete set of E. coli K-12 ORF archive): Unique resources for biological research. DNA Res. 2005, 12, 291–299. [Google Scholar] [CrossRef]
- Alekshun, M.N.; Levy, S.B. The mar regulon: Multiple resistance to antibiotics and other toxic chemicals. Trends Microbiol. 1999, 7, 410–413. [Google Scholar] [CrossRef] [PubMed]
- Holden, E.R.; Yasir, M.; Turner, A.K.; Wain, J.; Charles, I.G.; Webber, M.A. Genome-wide analysis of genes involved in efflux function and regulation within Escherichia coli and Salmonella enterica serovar Typhimurium. Microbiology 2023, 169, 001296. [Google Scholar] [CrossRef] [PubMed]
- Wojtkiewicz, P.; Biernacka, D.; Gorzelak, P.; Stupak, A.; Klein, G.; Raina, S. Multicopy suppressor analysis of strains lacking cytoplasmic peptidyl-prolyl cis/trans isomerases identifies three new PPIase activities in Escherichia coli that includes the DksA transcription factor. Int. J. Mol. Sci. 2020, 21, 5843. [Google Scholar] [CrossRef] [PubMed]
- Baird, L.; Lipinska, B.; Raina, S.; Georgopoulos, C. Identification of the Escherichia coli sohB gene, a multicopy suppressor of the HtrA (DegP) null phenotype. J. Bacteriol. 1991, 173, 5763–5770. [Google Scholar] [CrossRef] [PubMed]
- Strauch, K.L.; Johnson, K.; Beckwith, J. Characterization of degP, a gene required for proteolysis in the cell envelope and essential for growth of Escherichia coli at high temperature. J. Bacteriol. 1989, 171, 2689–2696. [Google Scholar] [CrossRef]
- Klein, G.; Stupak, A.; Biernacka, D.; Wojtkiewicz, P.; Lindner, B.; Raina, S. Multiple transcriptional factors regulate transcription of the rpoE gene in Escherichia coli under different growth conditions and when the lipopolysaccharide biosynthesis is defective. J. Biol. Chem. 2016, 291, 22999–23019. [Google Scholar] [CrossRef]
- Malinverni, J.C.; Silhavy, T.J. An ABC transport system that maintains lipid asymmetry in the gram-negative outer membrane. Proc. Natl. Acad. Sci. USA 2009, 106, 8009–8014. [Google Scholar] [CrossRef]
- Kolich, L.R.; Chang, Y.T.; Coudray, N.; Giacometti, S.I.; MacRae, M.R.; Isom, G.L.; Teran, E.M.; Bhabha, G.; Ekiert, D.C. Structure of MlaFB uncovers novel mechanisms of ABC transporter regulation. Elife 2020, 9, e60030. [Google Scholar] [CrossRef] [PubMed]
- Klein, G.; Lindner, B.; Brade, H.; Raina, S. Molecular basis of lipopolysaccharide heterogeneity in Escherichia coli: Envelope stress-responsive regulators control the incorporation of glycoforms with a third 3-deoxy-α-D-manno-oct-2-ulosonic acid and rhamnose. J. Biol. Chem. 2011, 286, 42787–42807. [Google Scholar] [CrossRef] [PubMed]
- Klein, G.; Müller-Loennies, S.; Lindner, B.; Kobylak, N.; Brade, H.; Raina, S. Molecular and structural basis of inner core lipopolysaccharide alterations in Escherichia coli: Incorporation of glucuronic acid and phosphoethanolamine in the heptose region. J. Biol. Chem. 2013, 288, 8111–8127. [Google Scholar] [CrossRef] [PubMed]
- Missiakas, D.; Raina, S. Signal transduction pathways in response to protein misfolding in the extracytoplasmic compartments of E. coli: Role of two new phosphoprotein phosphatases PrpA and PrpB. EMBO J. 1997, 16, 1670–1685. [Google Scholar] [CrossRef] [PubMed]
- Danese, P.N.; Silhavy, T.J. The σE and the Cpx signal transduction systems control the synthesis of periplasmic protein-folding enzymes in Escherichia coli. Genes Dev. 1997, 11, 1183–1193. [Google Scholar] [CrossRef]
- Price, N.L.; Raivio, T.L. Characterization of the Cpx regulon in Escherichia coli strain MC4100. J. Bacteriol. 2009, 191, 1798–1815. [Google Scholar] [CrossRef]
- Zhao, Z.; Xu, Y.; Jiang, B.; Qi, Q.; Tang, Y.J.; Xian, M.; Wang, J.; Zhao, G. Systematic identification of CpxRA-regulated genes and their roles in Escherichia coli stress response. mSystems 2022, 7, e0041922. [Google Scholar] [CrossRef] [PubMed]
- Fayet, O.; Ziegelhoffer, T.; Georgopoulos, C. The groES and groEL heat shock gene products of Escherichia coli are essential for bacterial growth at all temperatures. J. Bacteriol. 1989, 171, 1379–1385. [Google Scholar] [CrossRef]
- Shewmaker, F.; Kerner, M.J.; Hayer-Hartl, M.; Klein, G.; Georgopoulos, C.; Landry, S.J. A mobile loop order-disorder transition modulates the speed of chaperonin cycling. Protein Sci. 2004, 13, 2139–2148. [Google Scholar] [CrossRef] [PubMed]
- Mehla, J.; Liechi, G.; Morgenstein, R.M.; Caufield, J.H.; Hosseinnia, A.; Gagarinova, A.; Phanse, S.; Goodacre, N.; Brockett, M.; Sakhawalkar, N.; et al. ZapG (YhcB/DUF1043), a novel cell division protein in gamma-proteobacteria linking the Z-ring to septal peptidoglycan synthesis. J. Biol. Chem. 2021, 296, 100700. [Google Scholar] [CrossRef]
- Lee, J.H.; Lennon, C.W.; Ross, W.; Gourse, R.L. Role of the coiled-coil tip of Escherichia coli DksA in promoter control. J. Mol. Biol. 2012, 416, 503–517. [Google Scholar] [CrossRef] [PubMed]
- Parshin, A.; Shiver, A.L.; Lee, J.; Ozerova, M.; Schneidman-Duhovny, D.; Gross, C.A.; Borukhov, S. DksA regulates RNA polymerase in Escherichia coli through a network of interactions in the secondary channel that includes sequence insertion 1. Proc. Natl. Acad. Sci. USA 2015, 112, E6862–E6871. [Google Scholar] [CrossRef] [PubMed]
- Gourse, R.L.; Chen, A.Y.; Gopalkrishnan, S.; Sanchez-Vazquez, P.; Myers, A.; Ross, W. Transcriptional responses to ppGpp and DksA. Annu. Rev. Microbiol. 2018, 72, 163–184. [Google Scholar] [CrossRef]
- De Lay, N.R.; Cronan, J.E. Genetic interaction between the Escherichia coli AcpT phosphopantetheinyl transferase and the YejM inner membrane protein. Genetics 2008, 178, 1327–1337. [Google Scholar] [CrossRef] [PubMed][Green Version]
- Barbosa, T.M.; Levy, S.B. Differential expression of over 60 chromosomal genes in Escherichia coli by constitutive expression of MarA. J. Bacteriol. 2000, 182, 3467–3474. [Google Scholar] [CrossRef] [PubMed]
- Pomposiello, P.J.; Bennik, M.H.; Demple, B. Genome-wide transcriptional profiling of the Escherichia coli responses to superoxide stress and sodium salicylate. J. Bacteriol. 2001, 183, 3890–3902. [Google Scholar] [CrossRef]
- Sanchez-Vazquez, P.; Dewey, C.N.; Kitten, N.; Ross, W.; Gourse, R. Genome-wide effects on Escherichia coli transcription from ppGpp binding to its two sites on RNA polymerase. Proc. Natl. Acad. Sci. USA 2019, 116, 8310–8319. [Google Scholar] [CrossRef]
- White, D.G.; Goldman, J.D.; Demple, B.; Levy, S.B. Role of the acrAB locus in organic solvent tolerance mediated by expression of marA, soxS, or robA in Escherichia coli. J. Bacteriol. 1997, 179, 6122–6126. [Google Scholar] [CrossRef]
- Rhee, S.; Martin, R.G.; Rosner, J.L.; Davies, D.R. A novel DNA-binding motif in MarA: The first structure for an AraC family transcriptional activator. Proc. Natl. Acad. Sci. USA 1998, 95, 10413–10418. [Google Scholar] [CrossRef]
- Zhang, A.; Rosner, J.L.; Martin, R.G. Transcriptional activation by MarA, SoxS and Rob of two tolC promoters using one binding site: A complex promoter configuration for tolC in Escherichia coli. Mol. Microbiol. 2008, 69, 1450–1455. [Google Scholar] [CrossRef]
- Sharma, P.; Haycocks, J.R.J.; Middlemiss, A.D.; Kettles, R.A.; Sellars, L.E.; Ricci, V.; Piddock, L.J.V.; Grainger, D.C. The multiple antibiotic resistance operon of enteric bacteria controls DNA repair and outer membrane integrity. Nat. Commun. 2017, 8, 1444. [Google Scholar] [CrossRef] [PubMed]
- Betton, J.M.; Boscus, D.; Missiakas, D.; Raina, S.; Hofnung, M. Probing the structural role of an αβ loop of maltose-binding protein by mutagenesis: Heat-shock induction by loop variants of the maltose-binding protein that form periplasmic inclusion bodies. J. Mol. Biol. 1996, 262, 140–150. [Google Scholar] [CrossRef] [PubMed]
- Sugai, R.; Shimizu, H.; Nishiyama, K.; Tokuda, H. Overexpression of gnsA, a multicopy suppressor of the secG null mutation, increases acidic phospholipid contents by inhibiting phosphatidylethanolamine synthesis at low temperatures. J. Bacteriol. 2004, 186, 5968–5971. [Google Scholar] [CrossRef]
- Sugai, R.; Shimizu, H.; Nishiyama, K.; Tokuda, H. Overexpression of yccL (gnsA) and ydfY (gnsB) increases levels of unsaturated fatty acids and suppresses both the temperature-sensitive fabA6 mutation and cold-sensitive secG null mutation of Escherichia coli. J. Bacteriol. 2001, 183, 5523–5528. [Google Scholar] [CrossRef] [PubMed]
- Rock, C.O.; Jackowski, S. Regulation of phospholipid synthesis in Escherichia coli. Composition of the acyl-acyl carrier protein pool in vivo. J. Biol. Chem. 1982, 257, 10759–10765. [Google Scholar] [CrossRef]
- Butland, G.; Peregrín-Alvarez, J.M.; Li, J.; Yang, W.; Yang, X.; Canadien, V.; Starostine, A.; Richards, D.; Beattie, B.; Krogan, N.; et al. Interaction network containing conserved and essential protein complexes in Escherichia coli. Nature 2005, 433, 531–537. [Google Scholar] [CrossRef]
- Keating, D.H.; Carey, M.R.; Cronan, J.E., Jr. The unmodified (apo) form of Escherichia coli acyl carrier protein is a potent inhibitor of cell growth. J. Biol. Chem. 1995, 270, 22229–22235. [Google Scholar] [CrossRef]
- Bittner, L.M.; Westphal, K.; Narberhaus, F. Conditional proteolysis of the membrane protein YfgM by the FtsH protease depends on a novel N-terminal degron. J. Biol. Chem. 2015, 290, 19367–19378. [Google Scholar] [CrossRef] [PubMed]
- Lorenz, C.; Dougherty, T.J.; Lory, S. Transcriptional responses of Escherichia coli to a small-molecule inhibitor of LolCDE, an essential component of the lipoprotein transport pathway. J. Bacteriol. 2016, 198, 3162–3175. [Google Scholar] [CrossRef]
- Datsenko, K.A.; Wanner, B.L. One-step inactivation of chromosomal genes in Escherichia coli K-12 using PCR products. Proc. Natl. Acad. Sci. USA 2000, 97, 6640–6645. [Google Scholar] [CrossRef]
- Gully, D.; Bouveret, E. A protein network for phospholipid synthesis uncovered by a variant of the tandem affinity purification method in Escherichia coli. Proteomics 2006, 6, 282–293. [Google Scholar] [CrossRef] [PubMed]
- Galanos, C.; Lüderitz, O.; Westphal, O. A new method for the extraction of R lipopolysaccharides. Eur. J. Biochem. 1969, 9, 245–249. [Google Scholar] [CrossRef] [PubMed]
- Kondakova, A.; Lindner, B. Structural characterization of complex bacterial glycolipids by Fourier-transform mass spectrometry. Eur. J. Mass Spectrom. 2005, 11, 535–546. [Google Scholar] [CrossRef] [PubMed]
- Müller-Loennies, S.; Brade, L.; MacKenzie, C.R.; Di Padova, F.E.; Brade, H. Identification of a cross-reacting epitope widely present in lipopolysaccharide from enterobacteria and recognized by the cross-protective monoclonal antibody WN1 222-5. J. Biol. Chem. 2003, 278, 25618–25627. [Google Scholar] [CrossRef] [PubMed]
- Raina, S.; Missiakas, D.; Baird, L.; Kumar, S.; Georgopoulos, C. Identification and transcriptional analysis of the Escherichia coli htrE operon which is homologous to pap and related pilin operons. J. Bacteriol. 1993, 175, 5009–5021. [Google Scholar] [CrossRef]

| Growth Conditions | ||||
|---|---|---|---|---|
| Gene | LA 43 °C | MacConkey Agar 37 °C | ΔlapD | Function |
| yfgM | + | + | + | FtsH substrate, ancillary SecYEG translocon subunit |
| dksA | + | + | + | RNA polymerase-binding transcription factor |
| artJ | + | + | + | L-arginine ABC transporter periplasmic binding protein |
| acpP | + | + | + | acyl carrier protein |
| accB | + | - | + | biotin carboxyl carrier protein |
| lapD | + | ND | + | LPS assembly protein |
| pldA | + | - | - | outer membrane phospholipase A |
| marA | + | ± | - | DNA-binding transcriptional dual regulator |
| yceJ | + | - | - | putative cytochrome b561 |
| gnsA | + | - | - | putative phosphatidylethanolamine synthesis regulator |
| ymgG | + | - | ± | PF13436 family protein toxin-antitoxin system |
| srrA | + | + | + | transcription (stress response regulator A) |
| acpT | + | + | - | holo-(acyl carrier protein) synthase 2 |
| Numbers of Transductants on LA 30 °C | ||
|---|---|---|
| Donor | Wild Type | lapC190 |
| ΔmarA | 1274 | 92 1 |
| ΔsrrA | 650 | 2 |
| ΔdksA | >2000 | 163 2 |
| ΔpldA | 1460 | 34 tiny |
| ΔlpxL | 742 | 6 |
| ΔlpxM | 960 | 12 |
| ΔlapD | 733 | 25 |
| Numbers of Transductants on LA 30 °C | ||
|---|---|---|
| Donor | Wild Type | lapC190 |
| wild type + plpxL | lapC190 + plpxL | |
| P1 ΔlpxL | 1234 | 1164 |
| wild type + plpxM | lapC190 + plpxM | |
| P1 ΔlpxM | 968 | 1005 |
| wild type + plapD | lapC190 + plapD | |
| P1 ΔlapD | 811 | 840 |
| wild type + psrrA | lapC190 + psrrA | |
| P1 ΔsrrA | 794 | 736 |
| Recipient | P1 Donor | |||||
|---|---|---|---|---|---|---|
| 30 °C | 43 °C | |||||
| ΔmlaC | ΔmlaD | ΔmlaCD | ΔmlaC | ΔmlaD | ΔmlaCD | |
| wt BW25113 | 1260 | 1380 | 1429 | 1412 | 1274 | 980 |
| lapC190 (SR23583) | 623 | 710 | 690 | 12 | 14 | 9 |
| lapC190 + pmarA (SR23660) | 654 | 740 | 565 | 9 | 12 | 8 |
| Recipient | P1 Donor ΔclsA | |
|---|---|---|
| 30 °C | 43 °C | |
| wt | 840 | 759 |
| lapC190 + vector alone | 3 | - |
| lapC190 + psrrA+ with IPTG | 331 small colonies | 38 |
| Strains | Genotype | Reference |
|---|---|---|
| BW25113 | lacIq rrnBT14 ΔlacZWJ16 hsdR514 ΔaraBADAH33 ΔrhaBADLD78 | [70] |
| GK1942 | BW25113+pKD46 | [19] |
| W3110 | λ−, IN (rrnD-rrnE)1, rph-1 | CGSC, Yale |
| GK6075 | BW25113 lapC190<>cat | [6] |
| SR23529 | GK6075 lapC190<>frt | This study |
| SR23583 | BW25113 lapC190<>aph | This study |
| SR23679 | BW25113 lapD<>aph | [28] |
| SR23743 | SR23679 lapD<>frt | [28] |
| SR9073 | BW25113 mlaC<>aph | [42] |
| SR9078 | BW25113 mlaD<>aph | [42] |
| SR23627 | BW25113 mlaCD<>aph | This study |
| SR23630 | GK6075 mlaCD<>aph | This study |
| SR19957 | BW25113 srrA<>aph | [36] |
| SR23605 | BW25113 marA<>aph | This study |
| SR7092 | BW25113 clsA<>aph | Our collection |
| SR23320 | BW25113 clsA<>frt | [28] |
| SR20066 | BW25113 dksA<>aph | [36] |
| SR24224 | BW25113 pldA<>aph | This study |
| GK1275 | W3110 lpxM<>aph | [13] |
| GK1077 | W3110 lpxL<>aph | [13] |
| SR23941 | GK6075 lpxL<>aph msbA L412P | This study |
| SR23946 | GK6075 lpxM<>aph msbA L412P | This study |
| SR19761 | BW25113 + pCA24N | This study |
| SR23951 | SR23529 + psrrA+ | This study |
| SR23952 | SR23951 clsA::Tn10 | This study |
| SR23992 | SR23529 + pyfgM+ | This study |
| SR23994 | SR23529 + pdksA+ | This study |
| SR23996 | SR23529 + partJ+ | This study |
| SR23998 | SR23529 + pacpP+ | This study |
| SR24000 | SR23529 + paccB+ | This study |
| SR24027 | SR23529 + plapD+ | This study |
| SR24097 | SR23529 + ppldA+ | This study |
| SR23660 | SR23591 + pmarA+ | This study |
| SR24099 | SR23529 + pmarA+ mlaC<>aph | This study |
| SR24100 | SR23529 + pmarA+ mlaC::Tn10 | This study |
| SR24101 | SR23529 + pgnsA+ | This study |
| SR24103 | SR23529 + pyceJ+ | This study |
| SR24105 | SR23529 + pacpT+ | This study |
| SR24107 | SR23529 + pymgG+ | This study |
| GK3592 | BW25113 sfhC21 zad220::Tn10 ΔftsH3::Kan | [19] |
| SR24021 | SR23529 + pdksA+ | This study |
| SR24011 | SR23529 + pdksA D74N | This study |
| SR24013 | SR23529 + pdksA F82Y | This study |
| SR24015 | SR23529 + pdksA S83A | This study |
| SR24017 | SR23529 + pdksA L84A | This study |
| SR24019 | SR23529 + pdksA E85A | This study |
| SR24056 | SR23529 + plapD ΔN20 | This study |
| SR24058 | SR23529 + plapD (Δ100-132) | This study |
| SR24167 | SR23529 + plapD D69A Y70A R71A | This study |
| SR24170 | SR23529 + plapD L84A L85A P86A | This study |
| SR24173 | SR23529 + plapD N93A P94A F95A | This study |
| Plasmids | Genotype | Reference |
| pCA24N | IPTG-inducible expression vector cmR | [33] |
| pDUET | Expression vector | Our collection |
| pKD3 | oriR6Kg, bla(AmpR), kan, rgnB(Ter), cat | [70] |
| pKD13 | oriR6Kg, bla(AmpR), kan, rgnB(Ter) | [70] |
| pKD46 | araBp-gam-bet-exo, bla(AmpR), repA101(ts) | [70] |
| pCP20 | ts replicon with inducible FLP recombinase | [70] |
| pSR23599 | lapD+ in pDUET | This study |
| pSR22189 | dksA+ in pBR322 lacIq tetS ampR | [36] |
| pSR22505 | dksA+ D74N in pBR322 lacIq tetS ampR | [36] |
| pSR22511 | dksA+ F82Y in pBR322 lacIq tetS ampR | [36] |
| pSR22519 | dksA+ S83A in pBR322 lacIq tetS ampR | [36] |
| pSR22498 | dksA+ L84A in pBR322 lacIq tetS ampR | [36] |
| pSR22525 | dksA+ E85A in pBR322 lacIq tetS ampR | [36] |
| JW0141 | dksA+ in pCA24N cmR | [33] |
| JW0844 | artJ+ in pCA24N cmR | [33] |
| JW0976 | gnsA+ in pCA24N cmR | [33] |
| JW1044 | yceJ+ in pCA24N cmR | [33] |
| JW1080 | acpP+ in pCA24N cmR | [33] |
| JW2497 | yfgM+ in pCA24N cmR | [33] |
| JW3223 | accB+ in pCA24N cmR | [33] |
| JW3440 | acpT+ in pCA24N cmR | [33] |
| JW3794 | pldA+ in pCA24N cmR | [33] |
| JW5178 | ymgG+ in pCA24N cmR | [33] |
| JW5249 | marA+ in pCA24N cmR | [33] |
| JW5539 | lapD+ in pCA24N cmR | [33] |
| pSR14857 | srrA+ in pCA24N cmR | This study |
| pEB797 | pBAD-CBP-ACP (S36T) | [71] |
Disclaimer/Publisher’s Note: The statements, opinions and data contained in all publications are solely those of the individual author(s) and contributor(s) and not of MDPI and/or the editor(s). MDPI and/or the editor(s) disclaim responsibility for any injury to people or property resulting from any ideas, methods, instructions or products referred to in the content. |
© 2023 by the authors. Licensee MDPI, Basel, Switzerland. This article is an open access article distributed under the terms and conditions of the Creative Commons Attribution (CC BY) license (https://creativecommons.org/licenses/by/4.0/).
Share and Cite
Maniyeri, A.; Wieczorek, A.; Ayyolath, A.; Sugalska, W.; Klein, G.; Raina, S. Suppressors of lapC Mutation Identify New Regulators of LpxC, Which Mediates the First Committed Step in Lipopolysaccharide Biosynthesis. Int. J. Mol. Sci. 2023, 24, 15174. https://doi.org/10.3390/ijms242015174
Maniyeri A, Wieczorek A, Ayyolath A, Sugalska W, Klein G, Raina S. Suppressors of lapC Mutation Identify New Regulators of LpxC, Which Mediates the First Committed Step in Lipopolysaccharide Biosynthesis. International Journal of Molecular Sciences. 2023; 24(20):15174. https://doi.org/10.3390/ijms242015174
Chicago/Turabian StyleManiyeri, Akshay, Alicja Wieczorek, Aravind Ayyolath, Weronika Sugalska, Gracjana Klein, and Satish Raina. 2023. "Suppressors of lapC Mutation Identify New Regulators of LpxC, Which Mediates the First Committed Step in Lipopolysaccharide Biosynthesis" International Journal of Molecular Sciences 24, no. 20: 15174. https://doi.org/10.3390/ijms242015174
APA StyleManiyeri, A., Wieczorek, A., Ayyolath, A., Sugalska, W., Klein, G., & Raina, S. (2023). Suppressors of lapC Mutation Identify New Regulators of LpxC, Which Mediates the First Committed Step in Lipopolysaccharide Biosynthesis. International Journal of Molecular Sciences, 24(20), 15174. https://doi.org/10.3390/ijms242015174

